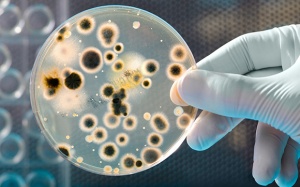
Nhiễm khuẩn là 'nguyên nhân gây tử vong thứ 2 trên toàn thế giới'

15/12/2022 11:30
Cảm lạnh là một trong những căn bệnh đường hô hấp hay gặp nhất trong mùa Đông. Bệnh không quá nguy hiểm nhưng thường gây khó chịu cho người mắc. Vậy cách phòng cảm lạnh thế nào?
07/12/2022 13:11
Bạn cần để tâm hơn đến đôi tay trong mùa Đông, do thời tiết hanh khô làm cho da tay dễ khô nẻ, ngứa ngáy. Một số lưu ý khi chăm sóc, dưỡng da tay sau đây giúp bàn tay luôn đẹp mịn màng.
22/11/2022 15:34
Nghiên cứu mới vừa được công bố trên Tạp chí Lancet cho thấy, nhiễm khuẩn là nguyên nhân gây tử vong đứng thứ hai trên toàn thế giới, chiếm 1/8 tổng số ca tử vong vào năm 2019. Đây cũng...
09/04/2021 07:51
Bệnh tay chân miệng là một trong những bệnh thường xuất hiện nhiều nhất ở môi trường học đường, đặc biệt là bậc mầm non. Vậy, cách phòng và ngăn ngừa bệnh tay chân miệng trong...
28/10/2020 16:21
Cảm cúm (cúm mùa) là một bệnh truyền nhiễm đường hô hấp cấp tính do virus cúm gây ra. Diễn biến của cảm cúm rất khó lường, thậm chí dẫn tới biến chứng và tử vong. Do đó, vào mùa...
27/10/2020 10:50
Trong điều kiện khan hiếm nước sạch và xà phòng, người dân có thể thực hiện một số biện pháp rửa tay sau để phòng ngừa Covid-19 và các bệnh về đường ruột.
04/08/2020 14:02
Những dung dịch tẩy rửa, xà phòng giúp sát khuẩn có thể gây khô da, bong tróc da tay. Biện pháp chăm sóc, làm mềm da tay sẽ giúp bạn bảo vệ đôi bàn tay mà vẫn đảm bảo các biện pháp ngăn...
08/05/2020 16:25
Hiện nay, vẫn chưa có một phương thuốc đặc trị nào dành cho virus corona. Vì vậy, cách tốt nhất để bảo vệ bản thân đó là phòng ngừa việc lây nhiễm Covid-19 và rửa tay là một trong...
31/03/2020 11:44
Hưởng ứng lời kêu gọi cả nước chung tay phòng, chống dịch COVID-19 từ Thủ tướng Chính phủ, Unilever vừa công bố khởi động chương trình “Vững vàng Việt Nam” với hàng loạt nỗ...
13/03/2020 11:29
Tổ chức Y tế Thế giới (WHO) công bố đại dịch toàn cầu khi virus SARS-CoV-2 lan rộng, ảnh hưởng đến nhiều quốc gia trên thế giới. Tâm lý hoang mang, hốt hoảng vì dịch bệnh cũng khiến...